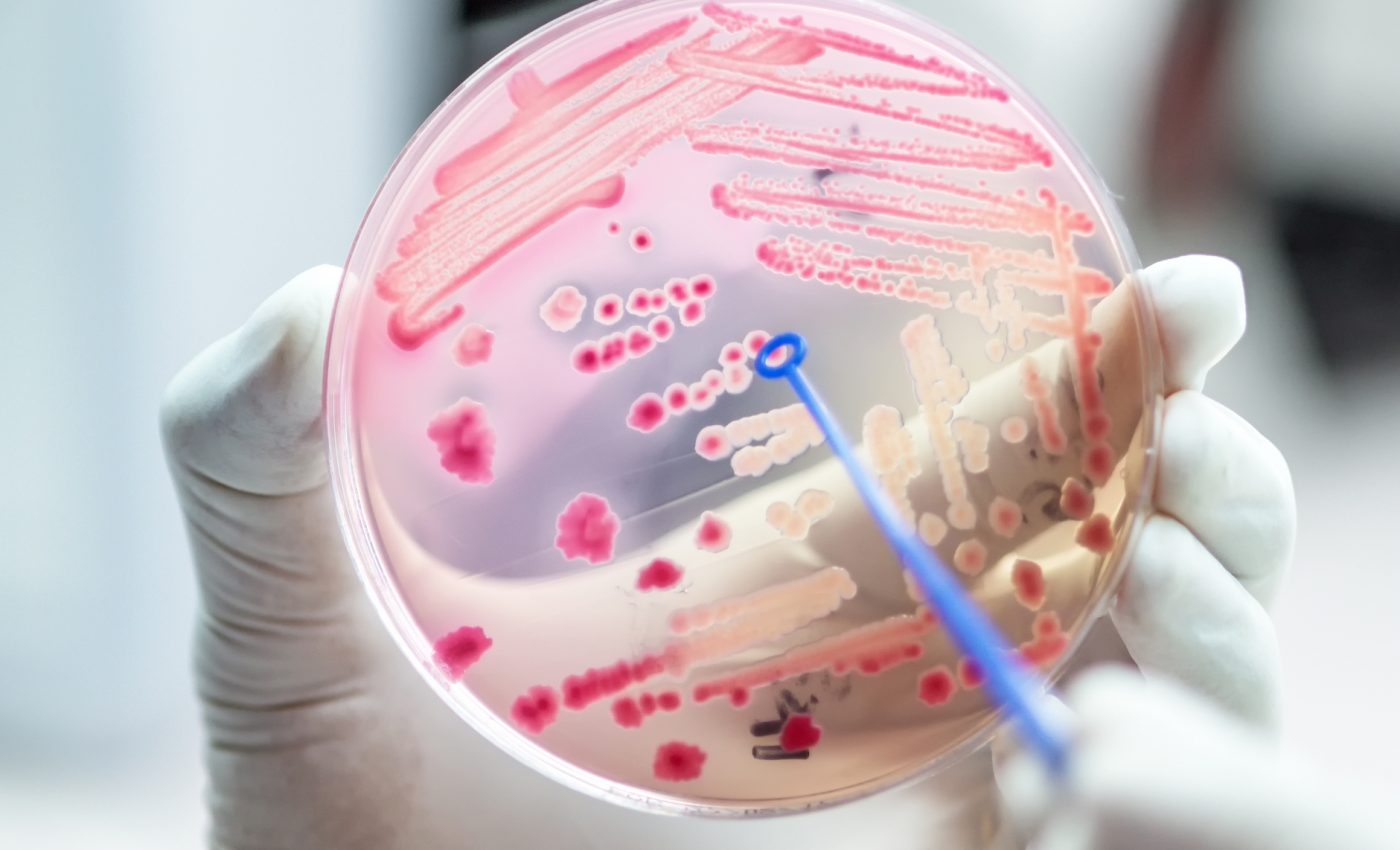
Research shows link between antimicrobial resistance and climate change

Research shows link between antimicrobial resistance and climate change
Research shows link between antimicrobial resistance and climate change. A collaborative study from the Institute of Infection Control and Infectious Diseases, University Medical Center Göttingen (UMG), and the Hannover Medical School (MHH), has shown an association between antimicrobial resistance (AMR) and climate change.
AMR was first linked to climate change when researchers noticed that resistance increased as temperatures warmed in the U.S. The study set out to determine if explanatory strength of climate factors can predict an increase of AMR, even in regions with diverse healthcare systems and communities. The researchers used Europe as a case region.
The team studied 30 countries across Europe and found via data published by the European Centre for Disease Prevention and Control (ECDC) a widespread, six-year-long presence of carbapenem resistant Pseudomonas aeruginosa (CRPA), Klebsiella pneumoniae (CRKP), multiresistant Escherichia coli (MREC), and Methicillin resistant Staphylococcus aureus (MRSA).
The then looked at the correlation between AMR and seasonal temperatures in each region, paying close attention to potential healthcare and socioeconomic factors that could be at play. Researchers were able to link CRKP, MREC and MRSA to warm-season mean temperature. CRPA was linked to warm-season change in temperature.
“Our study identified a novel association between AMR and climatic factors in Europe,” Professor Simone Scheithauer of UMG and her colleagues explain. “These results reveal two aspects: climatic factors significantly contribute to the prediction of AMR in different types of healthcare systems and societies, while climate change might increase AMR transmission, in particular carbapenem resistance.”
The authors continue, “While these results remain hypothetical as it is unknown if any causal association exists, future analysis of AMR and climatic developments is necessary to determine whether potential climate change effects on AMR become stronger.”
The findings will be presented at the April 13th European Congress of Clinical Microbiology & Infectious Diseases (ECCMID).
—
By Olivia Harvey, Earth.com Staff Writer
Paid for by Earth.com